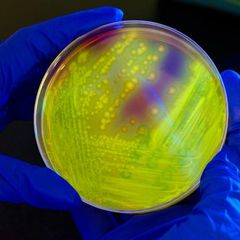

| |
Current News Review at 1 p.m. EST Daily
Current News: https://www.inoreader.com/stream/user/1006407045/tag/Current%20News/view/html?cs=m&sb=y
The News And Times - https://thenewsandtimes.blogspot.com/
Current Selected Articles: https://www.inoreader.com/stream/user/1006407045/tag/user-favorites/view/html
All Current Articles: https://www.inoreader.com/stream/user/1006407045/tag/all-articles/view/html |
|
 | Coco Gauff is 0-7 against No. 1 Iga Swiatek after losing to her in the French Open... |
| PARIS (AP) — This felt like a game Coco Gauff simply needed to claim if she intended to finally win a... |
 Associated Press News: Breaking News | Latest News Today Associated Press News: Breaking News | Latest News Today | now | |
|
 | Campaigners want fossil fuel firms to pay into climate calamity fund; diplomats dubious |
| BONN, Germany (AP) — Environmental campaigners called Wednesday for fossil fuel producers to contribute... |
 Associated Press News: Breaking News | Latest News Today Associated Press News: Breaking News | Latest News Today | now | |
|
| Senators plan briefings on AI to learn more about risks - Defense News |
| Senators plan briefings on AI to learn more about risks Defense News |
 "global threats to U.S. security" - Google News "global threats to U.S. security" - Google News | 1m | |
|
| ByteDance denies tracking users' personal data for China - Global Times |
| ByteDance denies tracking users' personal data for China Global Times |
 "global threats to U.S. security" - Google News "global threats to U.S. security" - Google News | 1m | |
|
| Russians shooting at rescuers in flooded areas, Zelenskyy says - POLITICO Europe |
| Russians shooting at rescuers in flooded areas, Zelenskyy says POLITICO Europe |
 "Crimean Bridge explosion" - Google News "Crimean Bridge explosion" - Google News | 1m | |
|
| Ukraine dam breach unleashes warmongering hysteria | Ukraine ... - In Defence of... |
| Ukraine dam breach unleashes warmongering hysteria | Ukraine ... In Defence of Marxism |
 "Crimean Bridge explosion" - Google News "Crimean Bridge explosion" - Google News | 1m | |
|
| Focus - As casualties mount, mobilisation tests Ukraine's social fabric - FRANCE... |
| Focus - As casualties mount, mobilisation tests Ukraine's social fabric FRANCE 24 English |
 "russia - ukraine war 2022" - Google News "russia - ukraine war 2022" - Google News | 2m | |
|
 | We Can Celebrate Women's Success Without Downplaying Men's |
| Commentary The crowd in the open-air tourist bus gazed up at the massive granite wall towering over... |
 The Epoch Times | The Epoch Times The Epoch Times | The Epoch Times | 2m | |
|
 | My 'Ivory Tower' Is in the Basement of a Suburban Split-Level |
| I got an interesting email (actually, it was more like a rant) from a guy who was upset about an encounter... |
 The Epoch Times | The Epoch Times The Epoch Times | The Epoch Times | 2m | |
|
| CDC Warns of Lethal Bacteria Detected Across US Gulf Coast |
| The CDC issued a warning about a deadly bacteria that can kill up to 50 percent of people it infects,... |
 The Epoch Times | The Epoch Times The Epoch Times | The Epoch Times | 2m | |
|
 | Joly Pledges Foreign-Service Reboot in Which Diplomats Better Grasp Languages, Topics |
| Foreign Affairs Minister Melanie Joly is promising a plan by this fall for a foreign-service reboot in... |
 The Epoch Times | The Epoch Times The Epoch Times | The Epoch Times | 2m | |
|
 | Car Bombing in Northeast Afghanistan Kills Local Official and His Driver, Wounds... |
| KABUL, Afghanistan—A car bombing in Afghanistan's northeast on Tuesday killed a provincial deputy governor... |
 The Epoch Times | The Epoch Times The Epoch Times | The Epoch Times | 2m | |
|
 | Wildfire, Shifting Winds Force Evacuation of Northern Quebec Communities |
| Residents of two northern Quebec communities are the latest to be hastily evacuated as a result of the... |
 The Epoch Times | The Epoch Times The Epoch Times | The Epoch Times | 2m | |
|
 | Conservatives Object as SPLC Designates Moms for Liberty 'Extremist Group' |
| The Southern Poverty Law Center (SPLC) has branded parental rights organization Moms for Liberty an anti-government... |
 The Epoch Times | The Epoch Times The Epoch Times | The Epoch Times | 2m | |
|
| Ukraine Dam Attack: Germany Calls It 'War Crime,' Blames Putin - Bloomberg |
| Ukraine Dam Attack: Germany Calls It 'War Crime,' Blames Putin Bloomberg |
 "Scholz and Putin" - Google News "Scholz and Putin" - Google News | 3m | |
|
| Implications of the Durham Report - Grahamstar |
| Implications of the Durham Report Grahamstar |
 "The Durham report" - Google News "The Durham report" - Google News | 4m | |
|
 | |
| @AP As Florida's governor has pushed anti-LGBTQ+ legislation, Jack Fitzgerald found support among fellow... |
 The Associated Press (Twitter) The Associated Press (Twitter) | 4m | |
|
 | |
| @AP Leo Burchell, a transgender student in Pennsylvania, had teachers' support when he transitioned in... |
 The Associated Press (Twitter) The Associated Press (Twitter) | 4m | |
|
 | |
| @AP Harmony Kennedy, 16, has experienced racism at her Tennessee school, where a classmate mocked the... |
 The Associated Press (Twitter) The Associated Press (Twitter) | 4m | |
|
| |
| For many students, new measures restricting how schools address race, gender and sexuality are having... |
 The Associated Press (Twitter) The Associated Press (Twitter) | 4m | |
|
| |
| BREAKING: Pope Francis has emerged from three hours of abdominal surgery without complications, the Vatican... |
 The Associated Press (Twitter) The Associated Press (Twitter) | 4m | |
|
| Media Watch: China's mixed signals on Russo-Ukrainian war - Radio Free Asia |
| Media Watch: China's mixed signals on Russo-Ukrainian war Radio Free Asia |
 "Putin and Xi Jinping" - Google News "Putin and Xi Jinping" - Google News | 4m | |
|
| Iowa Gov. Reynolds asks White House for help after partial building ... - KMTV 3... |
| Iowa Gov. Reynolds asks White House for help after partial building ... KMTV 3 News Now Omaha |
 "Iowa apartment collapse" - Google News "Iowa apartment collapse" - Google News | 5m | |
|
| Galway man jailed for 11 years for rape and sexual abuse of his young niece - Connacht... |
| Galway man jailed for 11 years for rape and sexual abuse of his young niece Connacht Tribune Group |
 "project raven" - Google News "project raven" - Google News | 5m | |
|
| Tulsa Shooting Injures 60-Year-Old Man; Suspected Shooter ... - news9.com KWTV |
| Tulsa Shooting Injures 60-Year-Old Man; Suspected Shooter ... news9.com KWTV |
 "Tulsa shooting" - Google News "Tulsa shooting" - Google News | 6m | |
|
| Grand Jury in Florida Hears Testimony in Trump Documents Case - The New York Times |
| Grand Jury in Florida Hears Testimony in Trump Documents Case The New York Times |
 "Mar-a-Lago documents" - Google News "Mar-a-Lago documents" - Google News | 7m | |
|
| Pope Francis' appointments canceled until June 18, Italian diocese says - Catholic... |
| Pope Francis' appointments canceled until June 18, Italian diocese says Catholic News Agency |
 "pope francis" - Google News "pope francis" - Google News | 10m | |
|
| Pope Francis, 86, Hospitalized for Abdominal Surgery: Vatican - The Daily Beast |
| Pope Francis, 86, Hospitalized for Abdominal Surgery: Vatican The Daily BeastPope Francis Is Out of... |
 "pope francis" - Google News "pope francis" - Google News | 10m | |
|
| Pope Francis adds Fátima visit to World Youth Day trip. Published ... - The Pilot |
| Pope Francis adds Fátima visit to World Youth Day trip. Published ... The Pilot |
 "pope francis" - Google News "pope francis" - Google News | 10m | |
|
| Russia claim about nuke-capable F-16s for Ukraine is nonsense: expert - Business... |
| Russia claim about nuke-capable F-16s for Ukraine is nonsense: expert Business Insider |
 "weapons for ukraine" - Google News "weapons for ukraine" - Google News | 13m | |
|
| Conservative Pundit Says 4 Things Show It's 'Gotten Very, Very Real' For Donald Trump... |
| Conservative Pundit Says 4 Things Show It's 'Gotten Very, Very Real' For Donald Trump Yahoo! Voices |
 "special counsel jack smith" - Google News "special counsel jack smith" - Google News | 13m | |
|
| Is Biden's industrial policy renewing or undoing the rules-based order? - The Hill |
| Is Biden's industrial policy renewing or undoing the rules-based order? The Hill |
 "National security adviser Jake Sullivan" - Google News "National security adviser Jake Sullivan" - Google News | 14m | |
|
| : Affirm's stock roars higher after expanded Amazon rollout |
| Shares of Affirm were flying 13% higher in Wednesday trading after the buy-now-pay-later operator saw... |
 Markets and Business News Review Markets and Business News Review | 14m | |
|
| : Lionel Messi to join MLS's Inter Miami, reports say |
| World Cup champion Lionel Messi is set to join Major League Soccer's Inter Miami. |
 Markets and Business News Review Markets and Business News Review | 14m | |
|
| : Visa, Mastercard stocks dip as Congress takes renewed aim at credit-card fees |
| Congress is taking another stab at regulating the card giants, and that's weighing on their shares even... |
 Markets and Business News Review Markets and Business News Review | 14m | |
|
| : GameStop's stock rallies as options traders prep for a big post-earnings move |
| GameStop's stock rocketed 35% the day after the last quarterly report and has averaged a gain of more... |
 Markets and Business News Review Markets and Business News Review | 14m | |
|
 | Undersea Connectors Show The Way To Globalization Of Electricity |
| At a time when it may be slowing in other sectors, globalization is booming in electricity. |
 Markets and Business News Review Markets and Business News Review | 14m | |
|
 | It's Official: Messi Picks Inter Miami Over Saudi Mega-Deal, Barcelona Reunion |
| Reports suggest Messi will turn down more than $300 million per year to head to Saudi Arabia in favor... |
 Markets and Business News Review Markets and Business News Review | 14m | |
|
 | Daily Dividend Report: Sun Communities, AECOM, The TJX Companies, Johnson Controls... |
| Daily Dividend Report: Sun Communities, AECOM, The TJX Companies, Johnson Controls International, UnitedHealth... |
 Markets and Business News Review Markets and Business News Review | 14m | |
|
 | 2023 NBA Finals: Michael Malone Implores The Denver Nuggets To Fix Defensive Mistakes |
| Heading into Game 3, Michael Malone sat down with his team during a film session and highlighted why... |
 Markets and Business News Review Markets and Business News Review | 14m | |
|
 | Taylor Swift's 'Midnights' Outsold The Next 31 Bestselling Albums In America This... |
| Taylor Swift's album Midnights has made a triumphant return to the top of the Billboard 200 chart this... |
 Markets and Business News Review Markets and Business News Review | 14m | |
|
 | CompX International's Cash Flow Increases The Safety Of Its Dividend Yield |
| CompX International (CIX) is the featured stock in May's Safest Dividend Yields Model Portfolio. |
 Markets and Business News Review Markets and Business News Review | 14m | |
|
 | Here's Where Air Quality Will Worsen As New York, Philadelphia And Toronto Are Blanketed... |
| Officials warn pollutants in the air can cause difficulty breathing, headaches and fatigue, and can be... |
 Markets and Business News Review Markets and Business News Review | 14m | |
|
| Economic Report: Homeowners are upbeat about the housing market — for one key reason,... |
| It sure feels like a great time to sell, but not to purchase a home, consumers said in a recent Fannie... |
 Markets and Business News Review Markets and Business News Review | 14m | |
|
| Key Words: Martha Stewart says she's opposed to remote work: 'Should America go down... |
| The lifestyle icon sounded off on the subject in a recent interview. |
 Markets and Business News Review Markets and Business News Review | 14m | |
|
 | The Debt Crisis That Wasn't: The New Normal That's Spooking Consumers |
| Discover the truth behind the so-called debt crisis and the looming sense of fear. Is it the new normal? |
 Markets and Business News Review Markets and Business News Review | 14m | |
|
| : Canadian wildfire smoke clouds some Global Running Day plans |
| Running clubs like the New York Road Runners are suggesting areas impacted by the wildfire smoke consider... |
 Markets and Business News Review Markets and Business News Review | 14m | |
|
| Key Words: AI community is 'making a terrible mistake' in hyping the tech, says Citadel's... |
| The AI community may regret its early hype around the technology, billionaire investor Ken Griffin warned. |
 Markets and Business News Review Markets and Business News Review | 14m | |
|
| Gorodnichenko, Sologoub: The Ukraine-Russia culture war - Kyiv Independent |
| Gorodnichenko, Sologoub: The Ukraine-Russia culture war Kyiv Independent |
 "Russian troops enter Donbas" - Google News "Russian troops enter Donbas" - Google News | 15m | |
|
| Ukrainian dam engineer rules out self-destruction of Kakhovka dam - Euromaidan Press |
| Ukrainian dam engineer rules out self-destruction of Kakhovka dam Euromaidan Press |
 "Russian troops enter Donbas" - Google News "Russian troops enter Donbas" - Google News | 15m | |
|
| Following delay, 'dead suspect loophole' bill sent to Gov. Abbott - Spectrum News |
| Following delay, 'dead suspect loophole' bill sent to Gov. Abbott Spectrum News |
 "Robb Elementary Uvalde" - Google News "Robb Elementary Uvalde" - Google News | 16m | |
|
| Erdogan suggests Zelensky to create international commission on ... - AzerNews.Az |
| Erdogan suggests Zelensky to create international commission on ... AzerNews.Az |
 "Zelensky" - Google News "Zelensky" - Google News | 16m | |
|
 | Ex-Italian prime minister and health minister cleared of Covid culpability |
| Court rules that Giuseppe Conte and Roberto Speranza not at fault over 6,000 excess deaths in Bergamo... |
 World news | The Guardian World news | The Guardian | 17m | |
|
 | UN climate talks might avoid fossil fuel phase-out, says Cop28 official |
| Majid Al Suwaidi says governments not in agreement yet over whether issue should be on agendaUN climate... |
 World news | The Guardian World news | The Guardian | 17m | |
|
| I'm not worried about Covid inquiry messages, says Rishi Sunak - BBC |
| I'm not worried about Covid inquiry messages, says Rishi Sunak BBC |
 "COVID" - Google News "COVID" - Google News | 17m | |
|
| Appeals court upholds convictions for Fort Myers man in COVID relief fraud case -... |
| Appeals court upholds convictions for Fort Myers man in COVID relief fraud case Yahoo News |
 "COVID" - Google News "COVID" - Google News | 17m | |
|
| Study: Heart Attack Outcomes Far Worse for Those With COVID-19 - Cedars-Sinai |
| Study: Heart Attack Outcomes Far Worse for Those With COVID-19 Cedars-Sinai |
 "COVID" - Google News "COVID" - Google News | 17m | |
|
| Mysterious COVID strain found in Ohio - WKBN.com |
| Mysterious COVID strain found in Ohio WKBN.com |
 "COVID" - Google News "COVID" - Google News | 17m | |
|
| Medicare scam: Allergy tests added on to COVID tests - Deseret News |
| Medicare scam: Allergy tests added on to COVID tests Deseret News |
 "COVID" - Google News "COVID" - Google News | 17m | |
|
| Russia's Putin Calls Ukraine Dam Attack A 'barbaric, Humanitarian ... - i24NEWS |
| Russia's Putin Calls Ukraine Dam Attack A 'barbaric, Humanitarian ... i24NEWS |
 "Zelensky and Putin" - Google News "Zelensky and Putin" - Google News | 17m | |
|
| State Emergency Service: Nearly 1,300 people evacuated from Kherson Oblast after... |
| State Emergency Service: Nearly 1,300 people evacuated from Kherson Oblast after Kakhovka dam explosion Kyiv... |
 "kyiv" - Google News "kyiv" - Google News | 18m | |
|
| Burkovskyi, Tarasiuk: Do Russian anti-Kremlin insurgents pose a real threat to Putin's... |
| Burkovskyi, Tarasiuk: Do Russian anti-Kremlin insurgents pose a real threat to Putin's regime? Kyiv... |
 "kyiv" - Google News "kyiv" - Google News | 18m | |
|
| Pro-Ukraine Group of Russian Partisans Plans to Give Prisoners to Kyiv - U.S. News... |
| Pro-Ukraine Group of Russian Partisans Plans to Give Prisoners to Kyiv U.S. News & World Report |
 "kyiv" - Google News "kyiv" - Google News | 18m | |
|
| Pope Francis has emerged from three hours of abdominal surgery without complications,... |
| |
 All Stories All Stories | 20m | |
|
| Kilauea, one of the world's most active volcanoes, begins erupting after 3-month... |
| |
 All Stories All Stories | 20m | |
|
| Police: Gunman who opened fire after high school graduation targeted graduate |
| |
 All Stories All Stories | 20m | |
|
 | Ernst Gottlieb Baron: Le Drole | Guitar Trio – Jakub Krnáč, Daniela Vavřinová, Alex... |
| Published, managed, & distributed by ISE Worldwide s.r.o.. Credit: Alex Kovaljov TV – https://www.youtube.com/@alexkovaljovtv4157... |
 The Epoch Times | The Epoch Times The Epoch Times | The Epoch Times | 21m | |
|
 | China Forcing US and Allies Out, Preparing for Blockade of Taiwan: Former Marine... |
| China is forcing the United States and its allies out of the region and preparing for a blockade of Taiwan... |
 The Epoch Times | The Epoch Times The Epoch Times | The Epoch Times | 21m | |
|
 | Federal Judge Denies Attempt to Block Washington State's New Gun Restrictions |
| On Tuesday, a federal judge denied an attempt to block Washington state's ban on the sale of semiautomatic... |
 The Epoch Times | The Epoch Times The Epoch Times | The Epoch Times | 21m | |
|
 | SEC Lawsuit Against Coinbase and Binance Sparks Controversy and Political Maneuvering |
| Commentary Yesterday, the Securities and Exchange Commission (SEC) fired a bombshell at the cryptocurrency... |
 The Epoch Times | The Epoch Times The Epoch Times | The Epoch Times | 21m | |
|
 | And Now the Problem of Exploding Hand Sanitizer |
| Commentary As COVID-19 blazed its path across the world, it sparked an insatiable demand for hand sanitizer,... |
 The Epoch Times | The Epoch Times The Epoch Times | The Epoch Times | 21m | |
|
 | Nationwide Lifeguard Shortage Could Force Half of US Pools to Close, Reduce Hours... |
| A nationwide lifeguard shortage threatens to shut down beaches and pools ahead of the busy summer holiday... |
 The Epoch Times | The Epoch Times The Epoch Times | The Epoch Times | 21m | |
|
 | |
| Great meeting with Saudi women leaders today in Riyadh. I am inspired by their courage and achievements.... |
 Secretary Antony Blinken (Twitter) Secretary Antony Blinken (Twitter) | 21m | |
|
| National Assembly speaker rules out vote to overturn French pension law - Yahoo Sport... |
| National Assembly speaker rules out vote to overturn French pension law Yahoo Sport Australia |
 "Scholz, Macron, Putin" - Google News "Scholz, Macron, Putin" - Google News | 22m | |
|
 | Italy rescues more than 1,400 migrants |
| More than 1,400 migrants have been rescued from overcrowded vessels, including a sailboat, in four separate... |
 Associated Press Associated Press | 23m | |
|
 | New drone video shows extent of flooding in Kherson |
| New Associated Press drone footage shows the extent of devastation in Kherson's Korabel district, after... |
 Associated Press Associated Press | 23m | |
|
 | NY mayor discusses city's air quality |
| New York City Mayor Eric Adams on Wednesday said air quality is deteriorating across the five boroughs... |
 Associated Press Associated Press | 23m | |
|
| NATO Secretary General discusses prospects for Ukraine, Vilnius ... - NATO HQ |
| NATO Secretary General discusses prospects for Ukraine, Vilnius ... NATO HQ |
 "Stoltenberg" - Google News "Stoltenberg" - Google News | 24m | |
|
| NATO needs to discuss security assurances for Kyiv – Stoltenberg - KFGO |
| NATO needs to discuss security assurances for Kyiv – Stoltenberg KFGO |
 "Stoltenberg" - Google News "Stoltenberg" - Google News | 24m | |
|
| U.S. General Says Russia Benefits From Dam Blast, Putin 'Likely' To Use Nuclear Weapons... |
| U.S. General Says Russia Benefits From Dam Blast, Putin 'Likely' To Use Nuclear Weapons Rather Than Lose... |
 "Crimean bridge" - Google News "Crimean bridge" - Google News | 25m | |
|
| U.S. Navy's largest aircraft carrier teams with Norway, U.K. militaries ... - DVIDS |
| U.S. Navy's largest aircraft carrier teams with Norway, U.K. militaries ... DVIDS |
 "global threats to U.S. security 2023" - Google News "global threats to U.S. security 2023" - Google News | 25m | |
|
 | |
| ISW retweeted: Before / after shots of the... |
 ISW (Twitter) ISW (Twitter) | 26m | |
|
 | |
| In this map, @WSJ incorporated data from WorldPop and @UNOCHA with ISW's mapping data of Russian-controlled... |
 ISW (Twitter) ISW (Twitter) | 26m | |
|
| Princeton Festival Celebrates Musical Diversity | A&E - Community News |
| Princeton Festival Celebrates Musical Diversity | A&E Community News |
 "mark t. rossini" - Google News "mark t. rossini" - Google News | 27m | |
|
| Trump town hall 'broke' the dam at CNN ahead of Chris Licht's departure, Joe Concha... |
| Trump town hall 'broke' the dam at CNN ahead of Chris Licht's departure, Joe Concha says Fox News |
 trump - Google News trump - Google News | 27m | |
|
| Chris Licht Out at CNN Weeks After Trump Town Hall Backlash - Newsweek |
| Chris Licht Out at CNN Weeks After Trump Town Hall Backlash Newsweek |
 trump - Google News trump - Google News | 27m | |
|
| Haberman: New evidence has people around Trump anxious - CNN |
| Haberman: New evidence has people around Trump anxious CNN |
 trump - Google News trump - Google News | 27m | |
|
 | Mexico president to meet with US transport chief on air-safety rating |
| 2023-06-07T16:02:34ZMexico's President Andres Manuel Lopez Obrador attends a press conference, at the... |
| |
|
 | El Salvador slashes size of Congress ahead of elections |
| 2023-06-07T16:00:13ZEl Salvador's Congress passed an electoral reform in the early hours of Wednesday... |
| |
|
 | Explainer: Where are the Canada wildfires and are they under control? |
| 2023-06-07T16:02:13ZWildfires are common in Canada's western provinces, but this year the eastern province... |
| |
|
 | Prince Harry: It would be injustice if court rules I"m not hacking victim |
| 2023-06-07T16:05:36ZPrince Harry returns to the High Court in London on Wednesday (June 7) for a second... |
| |
|
 | Yellen says U.S. inflation easing as some sectors slow, labor market strong |
| 2023-06-07T16:13:47ZU.S. Treasury Secretary Janet Yellen speaks during a news conference at the Treasury... |
| |
|
 | Biden aide Sullivan heads to India to prep for Modi state visit - sources |
| 2023-06-07T16:20:09ZPresident Joe Biden's national security adviser, Jake Sullivan, is headed to India... |
| |
|
| US announces reward for information on Swedish national charged with drug trafficking |
| 2023-06-07T16:22:06ZThe United States on Wednesday announced a reward of up to $5 million for information... |
| |
|
 | FBI says artificial intelligence being used for "sextortion" and harassment |
| 2023-06-07T15:55:34ZThe Federal Bureau of Investigation building, during afternoon hours, in Washington,... |
| |
|
| ODESSA'S GOT TALENT: Faith Bernabe - Yahoo News |
| ODESSA'S GOT TALENT: Faith Bernabe Yahoo News |
 "Odessa" - Google News "Odessa" - Google News | 28m | |
|
| Man accused of intentionally ramming into truck multiple times - KMID - Local 2 News |
| Man accused of intentionally ramming into truck multiple times KMID - Local 2 News |
 "Odessa" - Google News "Odessa" - Google News | 28m | |
|
| Ukraine's long-term future to be on agenda at Sunak and Biden ... - The Irish News |
| Ukraine's long-term future to be on agenda at Sunak and Biden ... The Irish News |
 "Biden in Kyiv 2023" - Google News "Biden in Kyiv 2023" - Google News | 29m | |
|
 | The world economy is changing—the people know, but their leaders ... - Peoples Dispatch |
| Peoples Dispatch |
 "ukraine neutrality" - Google News "ukraine neutrality" - Google News | 30m | |
|
| New Netanyahu adviser closes Twitter account following backlash - The Times of Israel |
| New Netanyahu adviser closes Twitter account following backlash The Times of Israel |
 "Biden in Israel" - Google News "Biden in Israel" - Google News | 31m | |



No comments:
Post a Comment